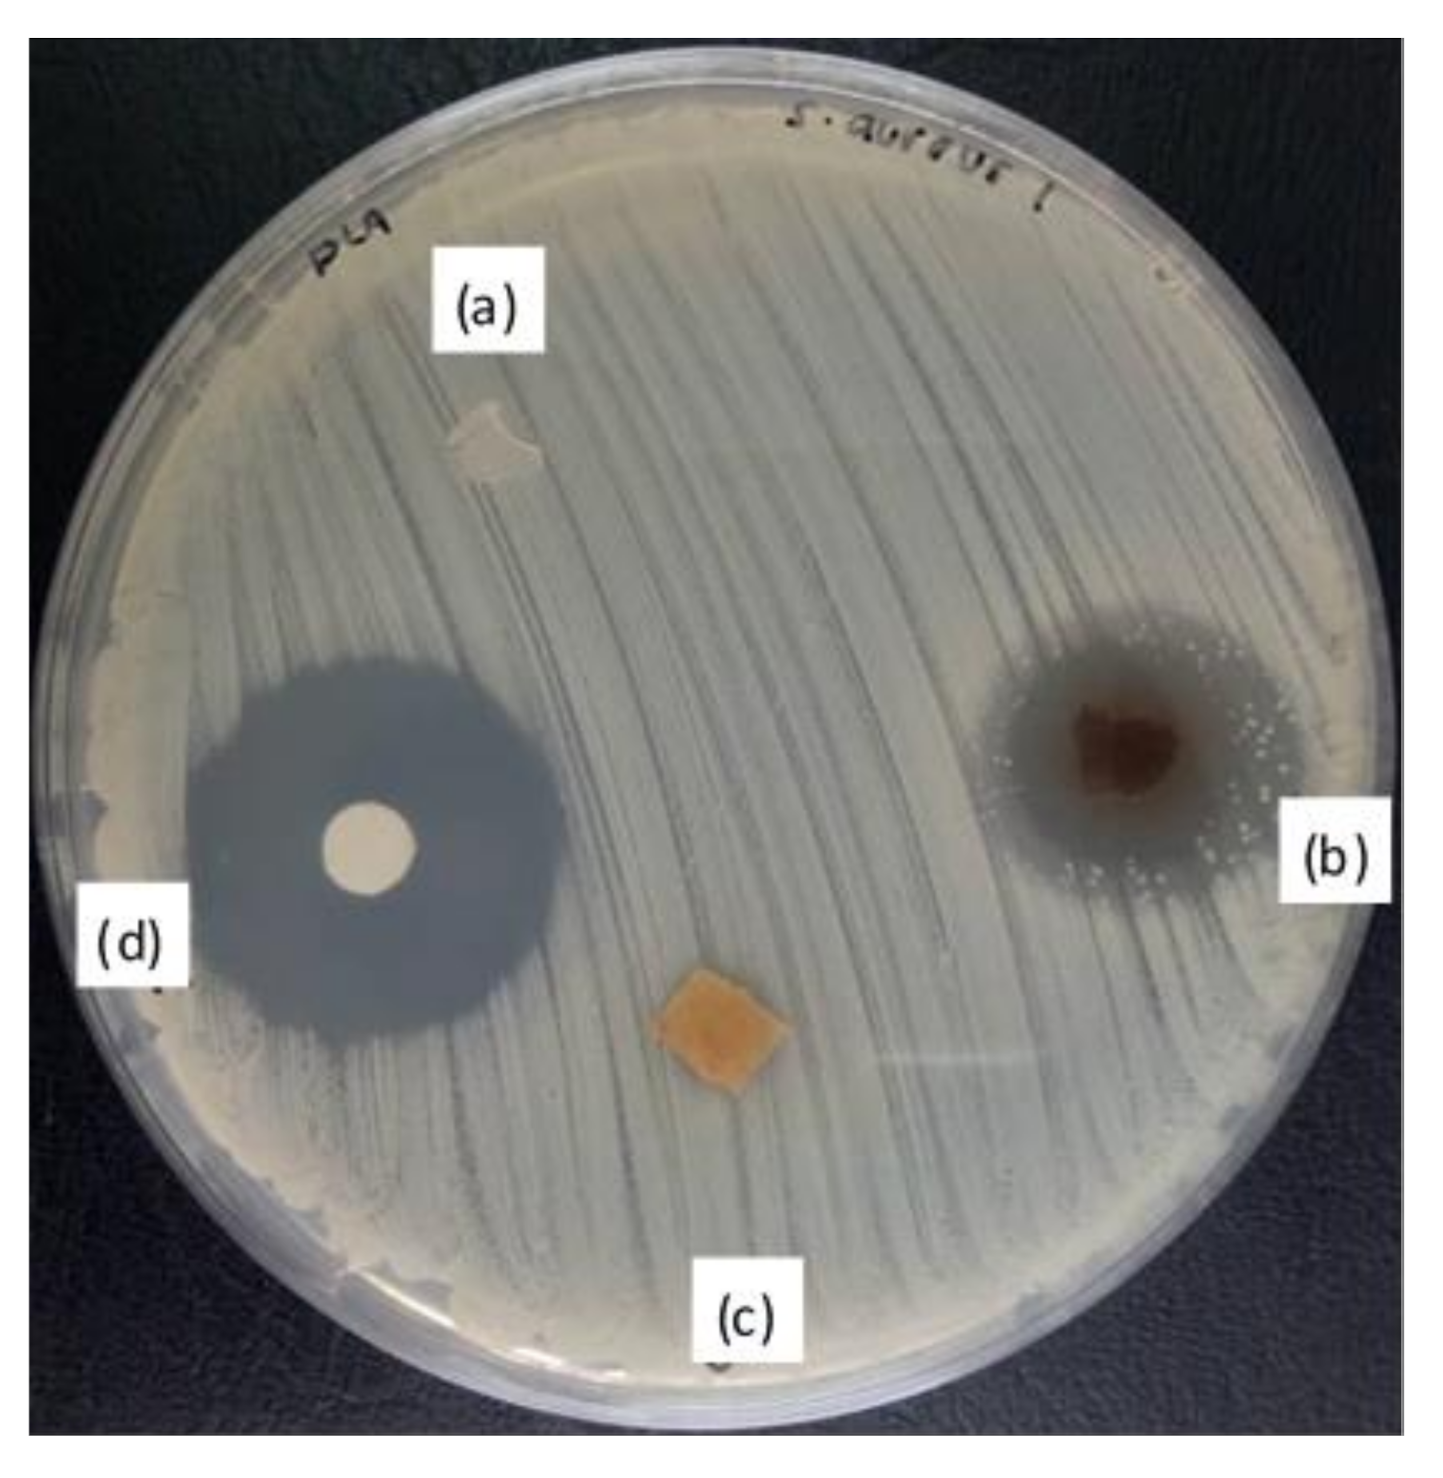
Polymers 12 02622 g011 Polymers 12 02622 g011

The Effect of Jackfruit Skin Powder and Fiber Bleaching Treatment in PLA Composites with Incorporation of Thymol
Abstract
1. Introduction
2. Materials and Methods
2.1. Materials
2.2. Preparation of Jackfruit Skin Powder (JSP)
2.3. Bleaching of Jackfruit Skin Powder (BJSP)
2.4. Preparation of PLA/JSP and PLA/BJSP Composites with Thymol
2.5. Composites Characteristics
2.5.1. Infrared Spectroscopy
2.5.2. Scanning Electron Microscopy
2.5.3. Tensile Testing
2.5.4. Thermogravimetric Analysis
2.5.5. Differential Scanning Calorimetry
2.5.6. Composite Degradation Test
2.5.7. Antimicrobial Activity
2.5.8. Statistical Analysis
3. Results and Discussions
3.1. SEM
3.2. FTIR
3.3. Mechanical Properties
3.4. Differential Scanning Calorimetry (DSC)
3.5. Thermogravimetric Analysis (TGA)
3.6. Decomposition in Compost
3.7. Antimicrobial Activity
4. Conclusions
Author Contributions
Funding
Acknowledgments
Conflicts of Interest
References
- Dashtizadeh, Z.; Khalina, A.; Cardona, F.; Lee, C.H. Mechanical Characteristics of Green Composites of Short Kenaf Bast Fiber Reinforced in Cardanol. Adv. Mater. Sci. Eng. 2019, 2019, 6. [Google Scholar] [CrossRef]
- Ayu, R.S.; Khalina, A.; Harmaen, A.S.; Zaman, K.; Jawaid, M.; Lee, C.H. Effect of Modified Tapioca Starch on Mechanical, Thermal, and Morphological Properties of PBS Blends for Food Packaging. Polymers 2018, 10, 1187. [Google Scholar] [CrossRef] [PubMed]
- Ayu, R.S.; Khalina, A.; Harmaen, A.S.; Zaman, K.; Mohd Nurrazi, N.; Isma, T.; Lee, C.H. Effect of Empty Fruit Brunch reinforcement in PolyButylene-Succinate/Modified Tapioca Starch blend for Agricultural Mulch Films. Sci. Rep. 2020, 10, 1166. [Google Scholar] [CrossRef] [PubMed]
- Lee, C.H.; Salit, M.S.; Hassan, M.R. A Review of the Flammability Factors of Kenaf and Allied Fibre Reinforced Polymer Composites. Adv. Mater. Sci. Eng. 2014, 2014, 8. [Google Scholar] [CrossRef]
- Ching hao, L.; Abdan, K.; Lee, S.H.; Liu, M. A Comprehensive Review on Bast Fibre Retting Process for Optimal Performance in Fibre-Reinforced Polymer Composites. Adv. Mater. Sci. Eng. 2020, 2020, 6074063. [Google Scholar]
- Ranasinghe, S.; Maduwanthi, T.; Marapana, R. Nutritional and Health Benefits of Jackfruit (Artocarpus heterophyllus Lam.): A Review. Int. J. Food Sci. 2019, 2019, 4327183. [Google Scholar] [CrossRef]
- Wignyanto, W.; Suprayogi, S. Optimization production of dry yeast using mixture of pineapple solid waste and liquid waste of fermented soybean industry. Int. Food Res. J. 2015, 22, 77–81. [Google Scholar]
- Aisyah, H.A.; Paridah, M.T.; Khalina, A.; Sapuan, S.M.; Wahab, M.S.; Berkalp, O.B.; Lee, C.H.; Lee, S.H. Effects of Fabric Counts and Weave Designs on the Properties of Laminated Woven Kenaf/Carbon Fibre Reinforced Epoxy Hybrid Composites. Polymers 2018, 10, 1320. [Google Scholar] [CrossRef]
- Sarebanha, S.; Farhan, A. Eco-friendly Composite Films Based on Polyvinyl Alcohol and Jackfruit Waste Flour. J. Packag. Technol. Res. 2018, 2, 181–190. [Google Scholar] [CrossRef]
- Ruma, S.; Rashid, F.; Sathi, M.; Rumy, N.; Saha, A.; Debnath, S.; Muslim, T.; Rahman, M. Isolation of Cellulosic Materials from Wastes of Fruits of Bangladesh and their Derivatization. Int. J. Adv. Pharm. Biol. Chem. 2014, 3, 400. [Google Scholar]
- Manshor, M.R.; Anuar, H.; Nur Aimi, M.N.; Ahmad Fitrie, M.I.; Wan Nazri, W.B.; Sapuan, S.M.; El-Shekeil, Y.A.; Wahit, M.U. Mechanical, thermal and morphological properties of durian skin fibre reinforced PLA biocomposites. Mater. Des. 2014, 59, 279–286. [Google Scholar] [CrossRef]
- Salahuddin, M.; Adila, N.; Syafinaz, M. Investigation on Oil Absorption and Microstructural Properties of Polyethylene Composites Reinforced with Post-agricultural Waste Fillers. In Advances in Material Sciences and Engineering; Springer: Singapore, 2020; pp. 343–352. [Google Scholar] [CrossRef]
- Ahmad, R.; Hamid, R.; Osman, S.A. Physical and chemical modifications of plant fibres for reinforcement in cementitious composites. Adv. Civil Eng. 2019, 2019, 5185806. [Google Scholar] [CrossRef]
- Rayung, M.; Ibrahim, N.; Zainuddin, N.; Saad, W.; Razak, N.; Chieng, B.W. The Effect of Fiber Bleaching Treatment on the Properties of Poly(lactic acid)/Oil Palm Empty Fruit Bunch Fiber Composites. Int. J. Mol. Sci. 2014, 15, 14728–14742. [Google Scholar] [CrossRef] [PubMed]
- Chan, H.; Chia, C.-H.; Zakaria, S.; Ahmad, I.; Dufresne, A. Production and Characterisation of Cellulose and Nano-Crystalline Cellulose from Kenaf Core Wood. BioResources 2012, 8. [Google Scholar] [CrossRef]
- Mustapha, A.; Jai, J.; Hamidon, F.; Sharif, Z.I.M.; Noorsuhana, M.Y. Antimicrobial agents from Malaysian plants and their potential use in food packaging material: Review. Chem. Eng. Res. Bull. 2017, 19, 57. [Google Scholar] [CrossRef]
- García-Salinas, S.; Elizondo-Castillo, H.; Arruebo, M.; Mendoza, G.; Irusta, S. Evaluation of the Antimicrobial Activity and Cytotoxicity of Different Components of Natural Origin Present in Essential Oils. Molecules 2018, 23, 1399. [Google Scholar] [CrossRef]
- Petchwattana, N.; Naknaen, P. Utilization of thymol as an antimicrobial agent for biodegradable poly(butylene succinate). Mater. Chem. Phys. 2015, 163, 369–375. [Google Scholar] [CrossRef]
- Marchese, A.; Erdogan Orhan, I.; Daglia, M.; Barbieri, R.; Di Lorenzo, A.; Nabavi, S.; Gortzi, O.; Izadi, M.; Nabavi, S. Antibacterial and antifungal activities of thymol: A brief review of the literature. Food Chem. 2016, 210, 402–414. [Google Scholar] [CrossRef]
- Tawakkal, I.S.M.A.; Cran, M.J.; Bigger, S.W. The influence of chemically treated natural fibers in poly(lactic acid) composites containing thymol. Polym. Compos. 2018, 39, 1261–1272. [Google Scholar] [CrossRef]
- Mohd Nazri, M.S.; Mohamed Amin Tawakka, I.S.; Khairuddin, N.; Talib, R.A.; Othman, S.H. Characterization of jackfruit straw-based films: Effect of starch and plasticizer contents. Pertanika J. Sci. Technol. 2019, 27, 1–14. [Google Scholar]
- Tawakkal, I.S.M.A.; Talib, R.A.; Abdan, K.; Ling, C.N. Mechanical and Physical Properties of Kenaf-Derived Cellulose (KDC)-Filled Polylactic Acid (PLA) Composites. Bioresources 2012, 7, 1643–1655. [Google Scholar] [CrossRef]
- Tawakkal, I.S.M.A.; Cran, M.J.; Bigger, S.W. Effect of kenaf fibre loading and thymol concentration on the mechanical and thermal properties of PLA/kenaf/thymol composites. Ind. Crop. Prod. 2014, 61, 74–83. [Google Scholar] [CrossRef]
- Ilyas, R.A.; Sapuan, S.; Ishak, M.; Zainudin, E.S. Effect of delignification on the physical, thermal, chemical, and structural properties of sugar palm fibre. BioResources 2017, 12, 8734–8754. [Google Scholar]
- Jonoobi, M.; Harun, J.; Tahir, P.M.; Zaini, L.; SaifulAzry, S.; Makinejad, M. Characteristics of nanofibers extracted from kenaf core. BioResources 2010, 5, 2556–2566. [Google Scholar]
- Sahari, J.; Sapuan, S.M.; Ismarrubie, Z.N.; Rahman, M.Z.A. Physical and Chemical Properties of Different Morphological Parts of Sugar Palm Fibres. Fibres Text. East. Eur. 2012, 91, 21–24. [Google Scholar]
- Ibrahim, N.; Yunus, W.; Othman, M.; Abdan, K. Effect of chemical surface treatment on the mechanical properties of reinforced plasticized poly(lactic acid) biodegradable composites. J. Reinf. Plast. Compos. 2011, 30, 381–388. [Google Scholar] [CrossRef]
- Pickering, K.; Ahmad, M.; Jayaraman, J.; Fernyhough, A. Influence of loading rate, alkali fibre treatment and crystallinity on fracture toughness of random short hemp fibre reinforced polylactide bio-composites. Compos. Part A Appl. Sci. Manuf. 2011, 42, 1148–1156. [Google Scholar] [CrossRef]
- Suradi, S.S.; Yunus, R.; Beg, H.; Rivai, M.; Yusof, Z.A.M. Oil Palm Bio-Fiber Reinforced Thermoplastic Composites-Effects of Matrix Modification on Mechanical and Thermal Properties. J. Appl. Sci. 2010, 10, 3271–3276. [Google Scholar] [CrossRef][Green Version]
- Liu, D.; Li, H.; Jiang, L.; Chuan, Y.; Yuan, M.; Chen, H. Characterization of Active Packaging Films Made from Poly(Lactic Acid)/Poly(Trimethylene Carbonate) Incorporated with Oregano Essential Oil. Molecules 2016, 21, 695. [Google Scholar] [CrossRef] [PubMed]
- Limpisophon, K.; Tanaka, M.; Osako, K. Characterisation of gelatin–fatty acid emulsion films based on blue shark (Prionace glauca) skin gelatin. Food Chem. 2010, 122, 1095–1101. [Google Scholar] [CrossRef]
- Sungsanit, K.; Kao, N.; Bhattacharya, S.N. Properties of linear poly(lactic acid)/polyethylene glycol blends. Polym. Eng. Sci. 2012, 52, 108–116. [Google Scholar] [CrossRef]
- Persico, P.; Ambrogi, V.; Carfagna, C.; Cerruti, P.; Ferrocino, I.; Mauriello, G. Nanocomposite polymer films containing carvacrol for antimicrobial active packaging. Polym. Eng. Sci. 2009, 49, 1447–1455. [Google Scholar] [CrossRef]
- Chun, K.S.; Husseinsyah, S.; Osman, H. Mechanical and thermal properties of coconut shell powder filled polylactic acid biocomposites: Effects of the filler content and silane coupling agent. J. Polym. Res. 2012, 19, 9859. [Google Scholar] [CrossRef]
- Seong, O.H.; Karevan, M.; Sim, I.N.; Bhuiyan, M.; Jang, Y.; Ghaffar, J.; Kalaitzidou, K. Understanding the Reinforcing Mechanisms in Kenaf Fiber/PLA and Kenaf Fiber/PP Composites: A Comparative Study. Int. J. Polym. Sci. 2012, 2012, 679252. [Google Scholar]
- Lee, C.H.; Sapuan, S.M.; Hassan, M.R. Thermal analysis of kenaf fiber reinforced floreon biocomposites with magnesium hydroxide flame retardant filler. Polym. Compos. 2018, 39, 869–875. [Google Scholar] [CrossRef]
- Farah, S.; Anderson, D.G.; Langer, R. Physical and mechanical properties of PLA, and their functions in widespread applications—A comprehensive review. Adv. Drug Deliv. Rev. 2016, 107, 367–392. [Google Scholar] [CrossRef]
- Lee, S.-H.; Wang, S. Biodegradable polymers/bamboo fiber biocomposite with bio-based coupling agent. Compos. Part A Appl. Sci. Manuf. 2006, 37, 80–91. [Google Scholar] [CrossRef]

| Composite | Fibre Powder Content (wt%) | Naming | Composite | Fibre Powder Content (wt%) | Thymol Content (wt%) | Naming |
|---|---|---|---|---|---|---|
| PLA | 0 | PLA | ||||
| Untreated JSP | 10 | 10JSP | PLA-THY | 0 | 5 | PLA-5THY |
| 20 | 20JSP | 0 | 10 | PLA-10THY | ||
| 30 | 30JSP | 0 | 15 | PLA-15THY | ||
| 40 | 40JSP | |||||
| Bleached JSP | 10 | 10BJSP | 30BJSP-THY | 30 | 5 | 30BJSP-5THY |
| 20 | 20BJSP | 30 | 10 | 30BJSP-10THY | ||
| 30 | 30BJSP | 30 | 15 | 30BJSP-15THY | ||
| 40 | 40BJSP |
| Sample | Tg (°C) | Tcc (°C) | Tm1 (°C) | Tm2 (°C) | ΔHcc (J/g) | ΔHm (J/g) |
|---|---|---|---|---|---|---|
| PLA | 59.69 | 101.99 | 151.27 | 155.58 | 21.72 | 32.63 |
| 10JSP | 57.69 | 98.17 | 150.74 | 154.99 | 15.16 | 27.85 |
| 10BJSP | 58.41 | 95.01 | 151.12 | 155.55 | 14.00 | 36.46 |
| 30JSP | 56.66 | 95.39 | 151.24 | 156.19 | 15.45 | 32.71 |
| 30BJSP | 57.61 | 96.76 | 152.53 | 157.13 | 13.41 | 33.34 |
| PLA-5THY | 51.60 | 93.87 | 145.72 | 151.50 | 14.94 | 25.96 |
| PLA-10THY | 40.38 | 86.96 | 140.05 | 147.27 | 16.47 | 23.42 |
| 30BJSP-5THY | 50.10 | - | 145.83 | - | - | 42.28 |
| 30BJSP-10THY | 39.50 | - | 129.79 | - | - | 36.18 |
Publisher’s Note: MDPI stays neutral with regard to jurisdictional claims in published maps and institutional affiliations. |
© 2020 by the authors. Licensee MDPI, Basel, Switzerland. This article is an open access article distributed under the terms and conditions of the Creative Commons Attribution (CC BY) license (http://creativecommons.org/licenses/by/4.0/).
Share and Cite
Marzuki, M.N.A.; Tawakkal, I.S.M.A.; Basri, M.S.M.; Othman, S.H.; Kamarudin, S.H.; Lee, C.H.; Khalina, A. The Effect of Jackfruit Skin Powder and Fiber Bleaching Treatment in PLA Composites with Incorporation of Thymol. Polymers 2020, 12, 2622. https://doi.org/10.3390/polym12112622
Marzuki MNA, Tawakkal ISMA, Basri MSM, Othman SH, Kamarudin SH, Lee CH, Khalina A. The Effect of Jackfruit Skin Powder and Fiber Bleaching Treatment in PLA Composites with Incorporation of Thymol. Polymers. 2020; 12(11):2622. https://doi.org/10.3390/polym12112622
Chicago/Turabian StyleMarzuki, Muhammad Najib Ahmad, Intan Syafinaz Mohamed Amin Tawakkal, Mohd Salahuddin Mohd Basri, Siti Hajar Othman, Siti Hasnah Kamarudin, Ching Hao Lee, and Abdan Khalina. 2020. "The Effect of Jackfruit Skin Powder and Fiber Bleaching Treatment in PLA Composites with Incorporation of Thymol" Polymers 12, no. 11: 2622. https://doi.org/10.3390/polym12112622
APA StyleMarzuki, M. N. A., Tawakkal, I. S. M. A., Basri, M. S. M., Othman, S. H., Kamarudin, S. H., Lee, C. H., & Khalina, A. (2020). The Effect of Jackfruit Skin Powder and Fiber Bleaching Treatment in PLA Composites with Incorporation of Thymol. Polymers, 12(11), 2622. https://doi.org/10.3390/polym12112622

